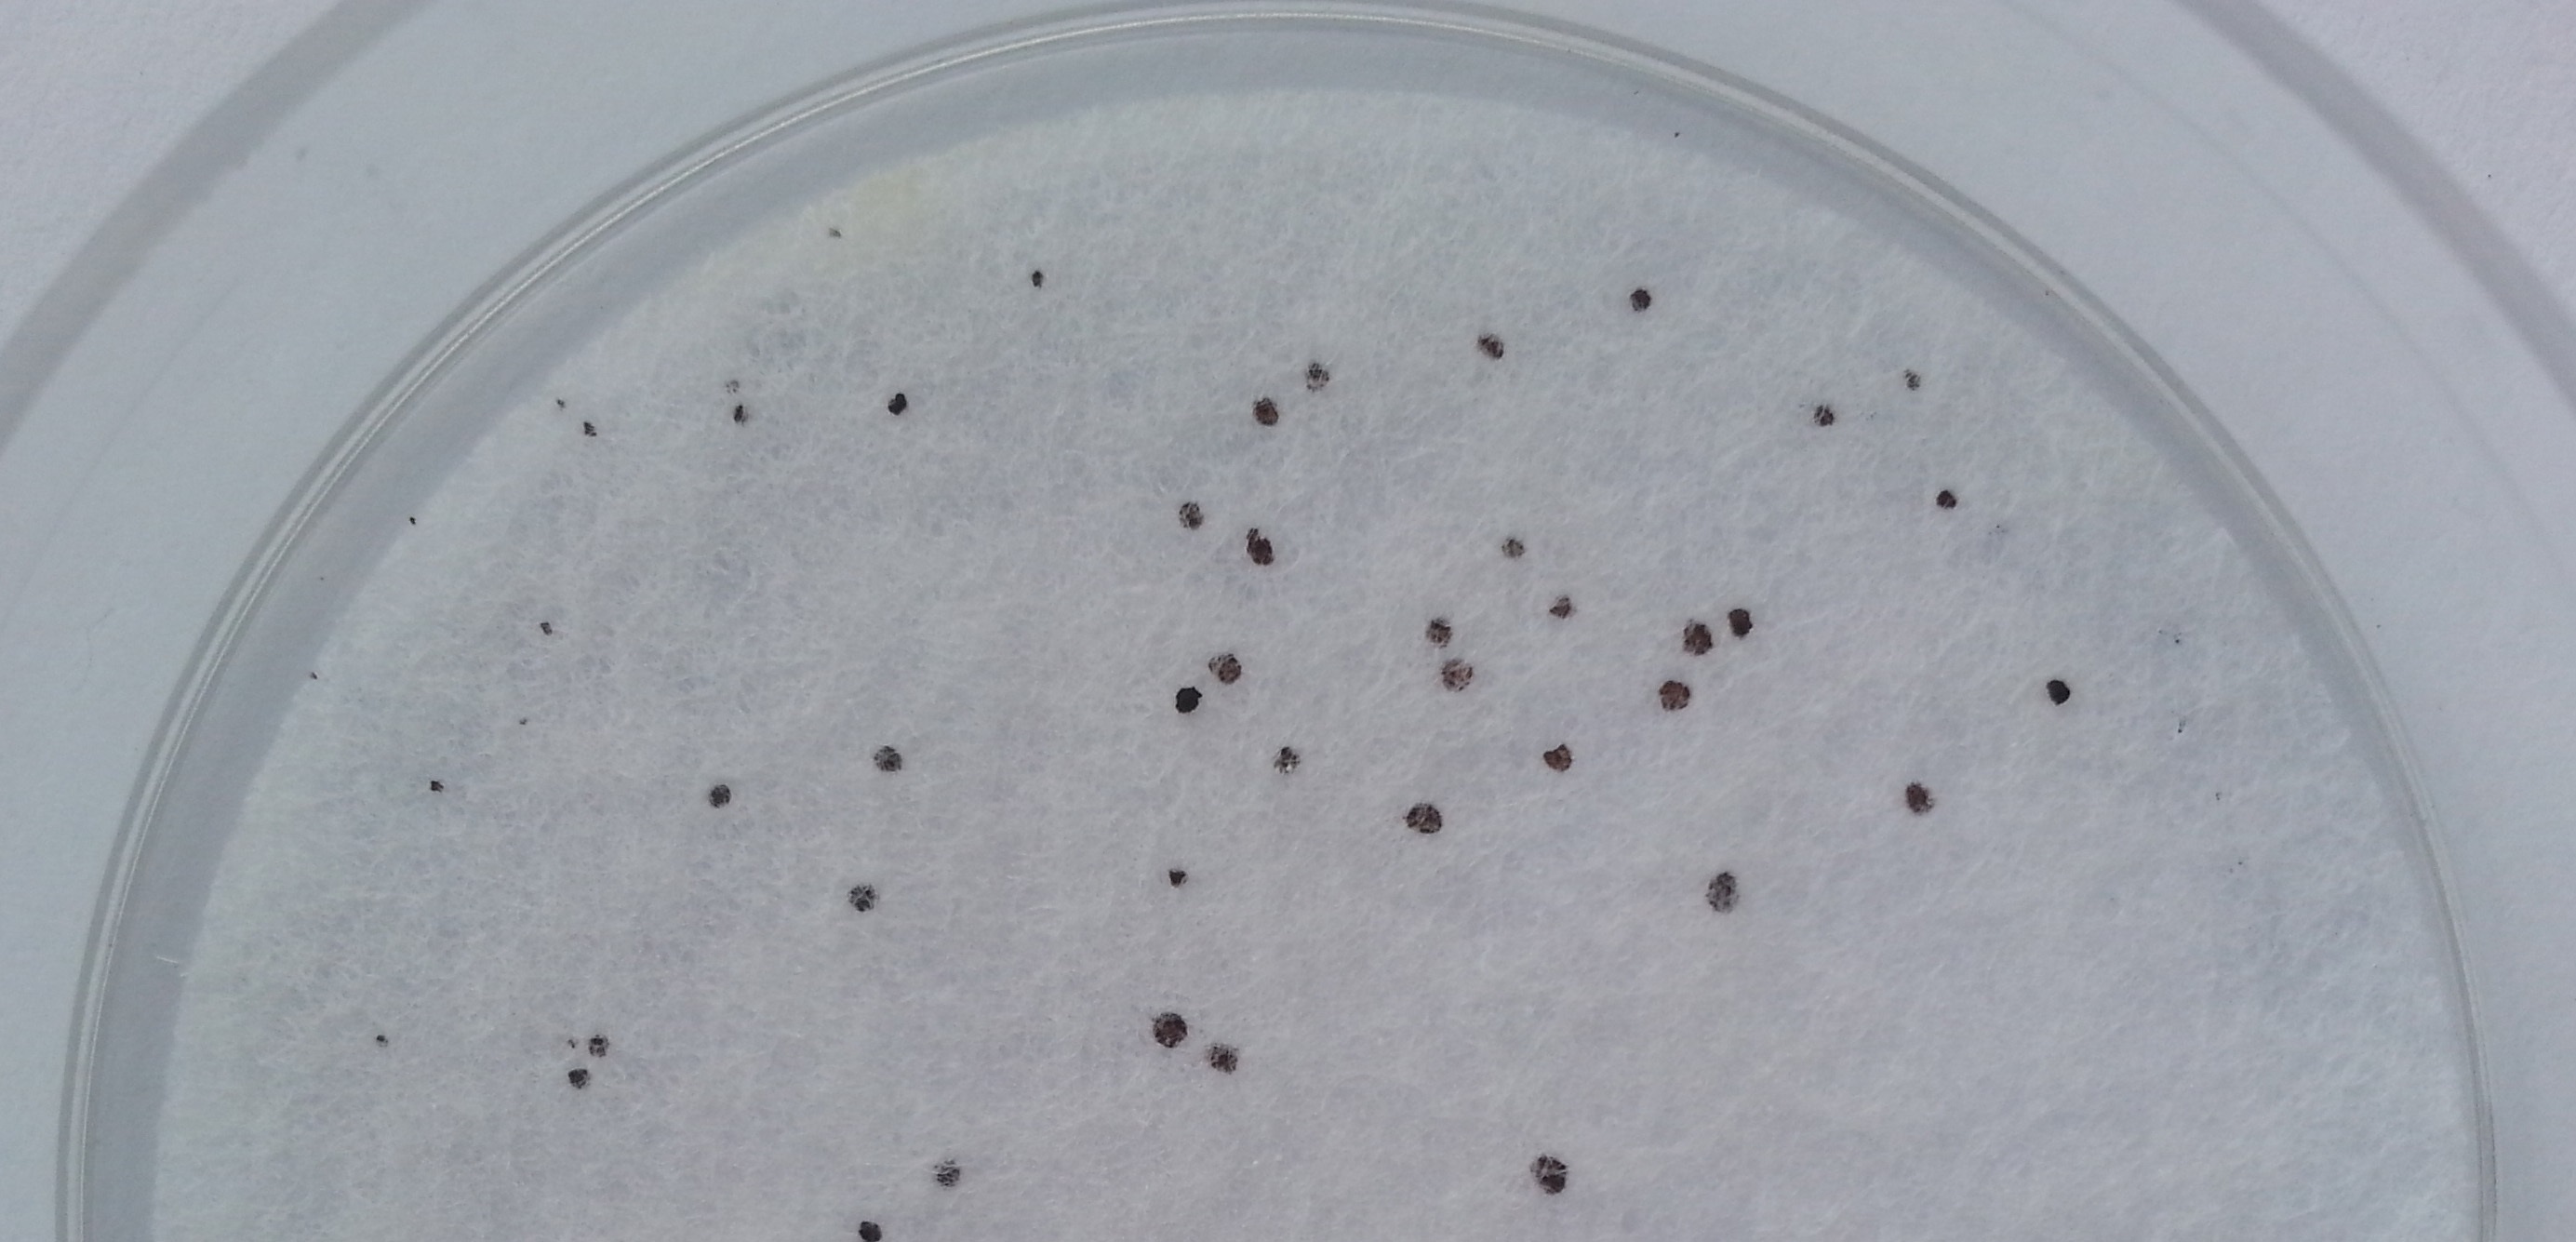

DryPlates® CAN: Detección Precoz de Candida albicans
Códigos: DPP016- (caja 60 u) y DPP016+ (caja 1200 u).
DryPlates® CAN son placas de cultivo preparadas con el medio Agar Biggy-Nickerson en un disco deshidratado estéril. Están listas para su uso inmediato, eliminando los largos procesos de preparación de medios agarizados.
Beneficios Clave y Detección Rápida
- Detección Precoz (16 h): Permite detectar Candida albicans en solo 16 horas, en comparación con los 1-2 días necesarios con el medio Biggy-Nickerson clásico. Esto es crucial para la liberación rápida de lotes en la industria farmacéutica y cosmética.
- Ahorro de Tiempo: Elimina el hervido, fusión y enfriado a de agares, ahorrando aproximadamente 2 horas de trabajo.
- Medio Selectivo y Diferencial: El Agar Biggy-Nickerson es normativo (ISO 18416) para la detección y recuento selectivo de C. albicans en muestras cosméticas y clínicas.
- Alta Recuperación: DryPlates® CAN logra recuperaciones incluso superiores a las obtenidas en el Agar Biggy tradicional y supera a los modernos medios cromogénicos.
- Larga Caducidad: 1 año desde su fabricación.
Identificación
Las colonias de Candida albicans crecen de color pardo, pequeñas y a menudo con márgenes lobulados. No hay difusión del pigmento al medio.
MODO DE EMPLEO
La inoculación de DryPlates® ocurre por hidratación del disco nutriente con la muestra líquida a temperatura ambiente.
A. Para Muestras Líquidas (1 ml)
- Preparar: Retire un disco nutriente con pinzas y colóquelo en la tapa de la placa recién abierta.
- Añadir la Muestra: Vierta 1 ml de la muestra líquida tratada en el centro de la base de la placa.
- Nota: Si la muestra es espesa, realice diluciones decimales hasta que sea acuosa.
- Cerrar e Inocular: Cierre la placa, permitiendo que el disco caiga sobre la muestra.
- Importante: Nunca añada la muestra sobre el disco, ya que esto reducirá la muestra captada y dará lugar a recuentos subestimados.
B. Para Muestras Líquidas Filtradas (100 ml, 250 ml, etc.)
- Prehidratar el Disco: Hidrate el disco nutriente de la placa con 1 ml de agua estéril. (Recuerde: disco sobre el agua, no al revés).
- Filtrar: Filtre la muestra (ej. ) a través de una membrana estéril ( o ).
- Revitalizar (Recomendado): Para evitar estresar las células de C. albicans, revitalice la membrana recién filtrada pasando a continuación de un tampón adecuado (ej. Buff. Peptone Solution ).
- Transferir: Deposite la membrana sobre el disco prehidratado de la DryPlates® CAN, evitando la formación de burbujas.
C. Para Ambientes Interiores (Superficies y Aires)
- Prehidratar: Hidrate la DryPlates® con 1 ml de agua estéril antes de la siembra (disco sobre el agua, no al revés).
- Superficies: Estríe sobre la placa un escobillón con el que haya barrido la superficie de la muestra.
- Aires: Deje la DryPlates® abierta durante 10-15 minutos en puntos críticos para una estimación «de campo» de la flora ambiental.
- (Para recuentos precisos por de aire, se recomienda mejor usar un muestreador com o MBS o Microflow).
Incubación y Lectura
Incubación
- Condiciones Estándar: durante .
- Posición: Sin voltear (disco abajo) para evitar fugas.
- Humedad (IMPORTANTE): Incubar en atmósfera húmeda (basta con un vaso de agua lleno en la estufa).
- Precaución: Nunca coloque la DryPlates® directamente sobre la bandeja metálica de la estufa. Intercale una placa vacía para evitar el secado por exceso de calor.
Detección Precoz y Revitalización
- Detección Rápida: Las cepas viables de crecerán desde las 16 horas como pequeñas colonias pardas y lobuladas.
- Revitalización: Si no aparecen estas minicolonias a las 16 horas, continúe incubando hasta 48 horas para permitir la revitalización de células dañadas o sub-letalmente estresadas.
Lectura de Resultados
Busque únicamente las colonias diana: C. albicans crece con colonias pardas, pequeñas, lobuladas, sin difusión del pigmento al medio.
Conservación y Precauciones de Uso
- Almacenamiento: Almacenar a temperatura ambiente (ideal ).
- ¡No refrigerar! La humedad de la nevera puede prehidratar y dañar los discos.
- Condiciones: Almacenar en un lugar muy seco y oscuro para proteger los medios deshidratados de la humedad y la luz.
- Alta Humedad: En zonas de alta humedad atmosférica, guarde las DryPlates® cerradas en su bolsa original dentro de un recipiente hermético («tupper») con sacos antihumedad.
Diseño y fabricación 100% españoles. Derechos de explotación de la PATENTE concedidos a dos empresas: Laboratorios MICROKIT, S.L. (Madrid) y BC Aplicaciones Analiticas, S.A (Barcelona) tras más de 8 años de ensayos y mejoras en sinergia para poder ofrecerle el mejor y más versátil producto de estas características.
DryPlates® es marca registrada por Laboratorios MICROKIT, S.L.
Para más información no dude en ponerse en contacto con nosotros a través de nuestro correo electrónico microkit@microkit.es o por teléfono en el nº 91-897 46 16
https://www.microkit.es/fichas/Dry-Plates-CANDI-Prospecto.pdf
Haga sus consultas de este medio en: microkit@microkit.es
Haga sus pedidos de este medio en: pedidos@microkit.es
En este vídeo puedes entender mejor la hazaña de las DryPlates® y cómo usarlas: